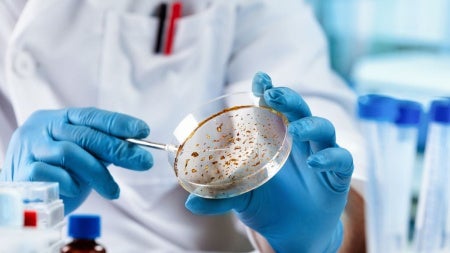
microbiologist

Chris King, a professor of pathology affiliated with the Center for Global Health and Diseases, and Catherine Bjerum, a senior research associate, were part of a team recognized with the 2021 Emeritage Centre Suisse de Recherches Scientifiques en Côte d'Ivoire (CSRS) Prize for Scientific Research. The award honors work on studies on the elimination of lymphatic filariasis and malaria.
The prize recognizes researchers for the excellence of their contribution to scientific research pursued in partnership between scientific institutions in the North and in Côte d'Ivoire and/or in other countries of West Africa.
The team was led by Benjamin Koudou, who worked with Tchikaya Emile, Allassane Quattara and Edi Constant, and collaborated with King, Bjerum, and Pie Muller.
The prize is awarded for high-quality research that has led to innovative applications and/or important peer-reviewed publications. King continues to participate—and in some cases lead—international research programs in Africa and Papua New Guinea for the treatment and elimination of parasitic infections of global health significance.